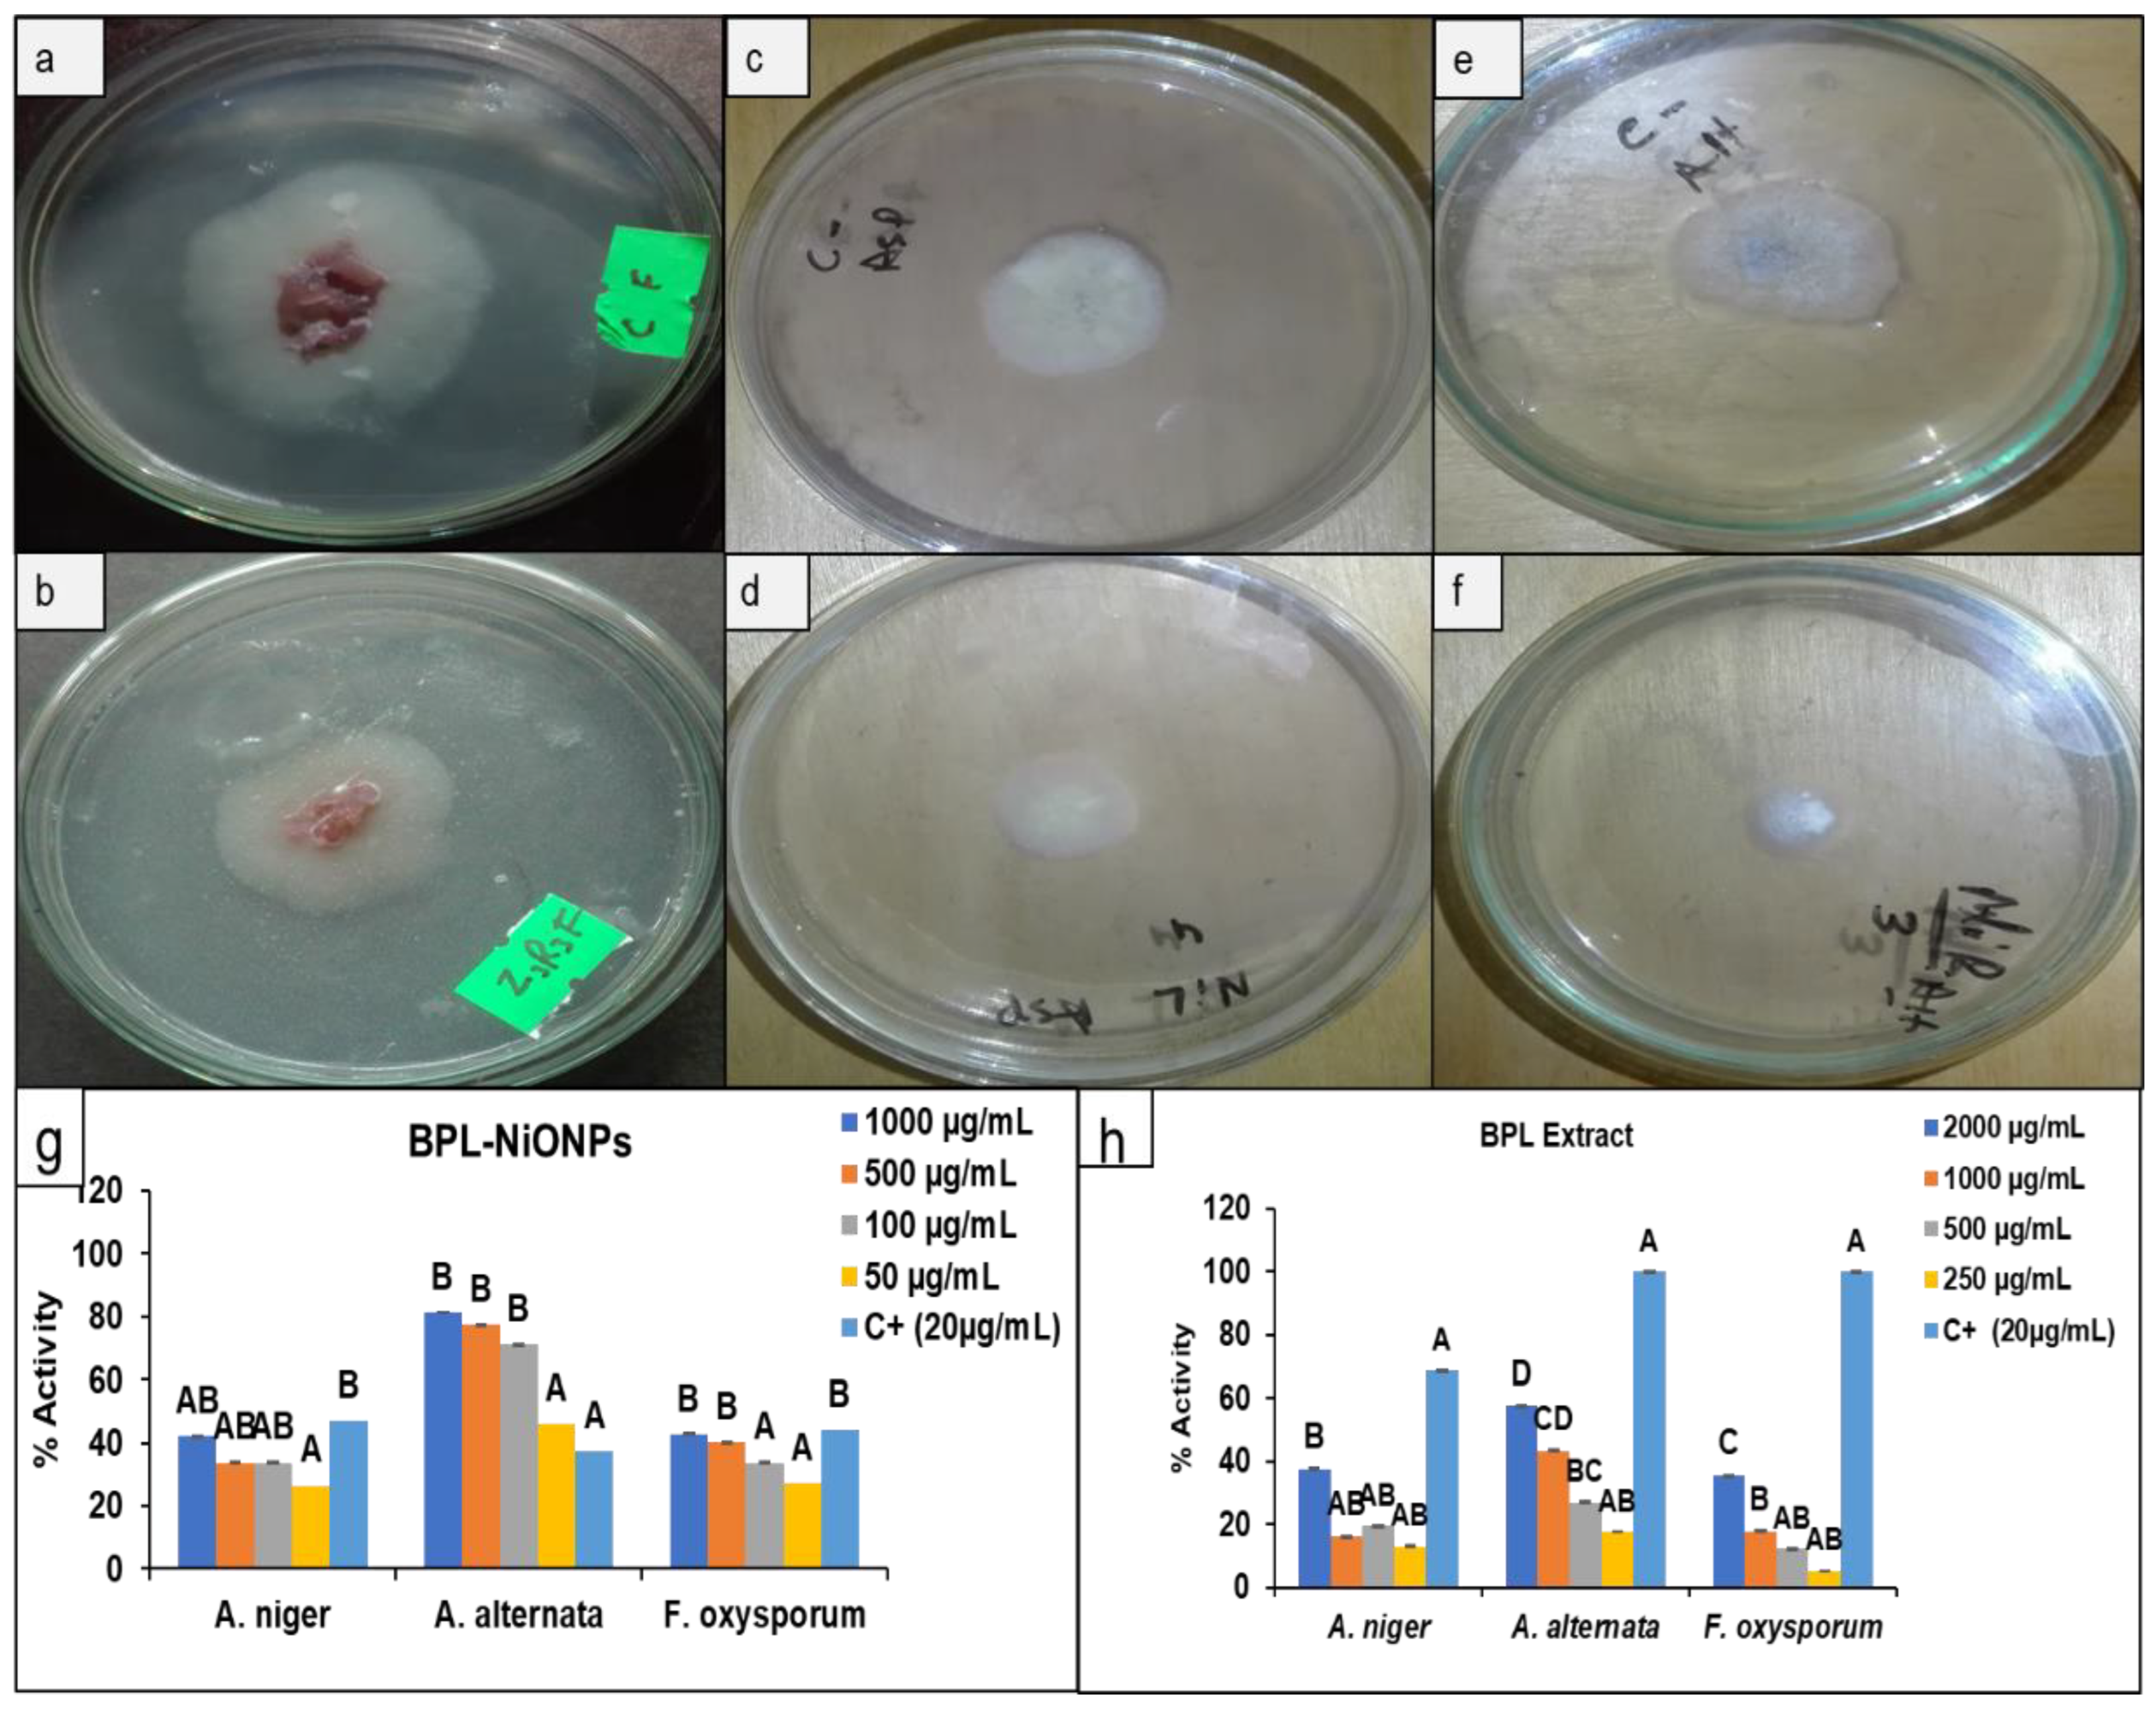

Green Synthesis of BPL-NiONPs Using Leaf Extract of Berberis pachyacantha: Characterization and Multiple In Vitro Biological Applications
Abstract
1. Introduction
2. Results
2.1. Physical Characterization of BPL Extract
2.1.1. UV-VIS Analysis
2.1.2. FTIR Analysis
2.2. Phytochemical Analysis of BPL Extract
Total Phenolic and Flavonoid Contents
2.3. Physical Characterization of BPL-NiONPs
2.4. Comparative Biological Analysis of BPL Extract and BPL-NiONPs
2.4.1. Antioxidant Potential
2.4.2. Antimicrobial Potential of BPL Extract and BPL-NiONPs
2.4.3. Mycelial Growth in Inhibition
2.4.4. Cytotoxic Activity
2.4.5. Stimulatory and Inhibitory Potential
3. Discussion
3.1. Analysis of BPL Extracts
3.2. Analysis of Green Synthesized BPL-NiONPs
3.2.1. Spectroscopic Screening of BPL-NiONPs
3.2.2. Biological Analysis of BPL-NiONPs
3.2.3. Stimulatory Effect and Phytotoxic Effect
4. Materials and Methods
4.1. Berberis pachyancantha (BP)
4.1.1. Plant Collection
4.1.2. Berberis pachyancantha Leaf (BPL) Extracts Preparation
4.2. Green Synthesis of BPL-NiONPs
4.2.1. The BPL Assisted Synthesis of NiONPs
4.2.2. Characterization of BPL-NiONPs
4.3. Biological Analysis of BPL Extract and BPL Mediated NiONPs
4.3.1. Total Phenolic and Total Flavonoid Contents Analysis (TPC and TFC)
4.3.2. 2,2-Diphenyl-1-picrylhydrazyl Assay (DPPH)
4.3.3. Total Antioxidant Capacity (TAC)
4.3.4. Antimicrobial Activities Using Agar Well Diffusion Method (AWDM)
4.3.5. Antifungal Assay Using Poisoned Food Method (PFM)
4.3.6. Cytotoxic Assay Using Brine Shrimp Lethality Assay (BSLA)
4.3.7. Phytotoxicity Assay Using Radish Seed Assay (RSA)
4.3.8. Statistical Analysis
5. Conclusions
Author Contributions
Funding
Institutional Review Board Statement
Informed Consent Statement
Data Availability Statement
Acknowledgments
Conflicts of Interest
Sample Availability
References
- Iqbal, J.; Abbasi, B.A.; Munir, A.; Uddin, S.; Kanwal, S.; Mahmood, T. Facile green synthesis approach for the production of chromium oxide nanoparticles and their different in vitro biological activities. Microsc. Res. Tech. 2020, 83, 706–719. [Google Scholar] [CrossRef] [PubMed]
- Abbasi, B.A.; Iqbal, J.; Ahmad, R.; Zia, L.; Kanwal, S.; Mahmood, T.; Chen, J.T. Bioactivities of Geranium wallichianum leaf extracts conjugated with zinc oxide nanoparticles. Biomolecules 2020, 10, 38. [Google Scholar] [CrossRef] [PubMed]
- Abbasi, B.A.; Iqbal, J.; Nasir, J.A.; Zahra, S.A.; Shahbaz, A.; Uddin, S.; Mahmood, T. Environmentally friendly green approach for the fabrication of silver oxide nanoparticles: Characterization and diverse biomedical applications. Microsc. Res. Tech. 2020, 83, 1308–1320. [Google Scholar] [CrossRef]
- Uddin, S.; Safdar, L.B.; Iqbal, J.; Yaseen, T.; Laila, S.; Anwar, S.; Quraishi, U.M. Green synthesis of nickel oxide nanoparticles using leaf extract of Berberis balochistanica: Characterization, and diverse biological applications. Microsc. Res. Tech. 2021, 84, 2004–2016. [Google Scholar] [CrossRef] [PubMed]
- Uddin, S.; Safdar, L.B.; Anwar, S.; Iqbal, J.; Laila, S.; Abbasi, B.A.; Quraishi, U.M. Green synthesis of nickel oxide nanoparticles from Berberis balochistanica stem for investigating bioactivities. Molecules 2021, 26, 1548. [Google Scholar] [CrossRef] [PubMed]
- Abbasi, B.A.; Iqbal, J.; Zahra, S.A.; Shahbaz, A.; Kanwal, S.; Rabbani, A.; Mahmood, T. Bioinspired synthesis and activity characterization of iron oxide nanoparticles made using Rhamnus Triquetra leaf extract. Mater. Res. Express 2020, 6, 1250e7. [Google Scholar] [CrossRef]
- Abbasi, B.A.; Iqbal, J.; Mahmood, T.; Ahmad, R.; Kanwal, S.; Afridi, S. Plant-mediated synthesis of nickel oxide nanoparticles (NiO) via Geranium wallichianum: Characterization and different biological applications. Mater. Res. Express 2019, 6, 0850a7. [Google Scholar] [CrossRef]
- Abbasi, B.A.; Iqbal, J.; Mahmood, T.; Qyyum, A.; Kanwal, S. Biofabrication of iron oxide nanoparticles by leaf extract of Rhamnus virgata: Characterization and evaluation of cytotoxic, antimicrobial and antioxidant potentials. Appl. Organomet. Chem. 2019, 33, e4947. [Google Scholar] [CrossRef]
- Končić, M.Z.; Kremer, D.; Karlović, K.; Kosalec, I. Evaluation of antioxidant activities and phenolic content of Berberis vulgaris L. and Berberis croatica Horvat. Food Chem. Toxicol. 2010, 48, 2176–2180. [Google Scholar] [CrossRef]
- Hameed, S.; Iqbal, J.; Ali, M.; Khalil, A.T.; Abbasi, B.A.; Numan, M.; Shinwari, Z.K. Green synthesis of zinc nanoparticles through plant extracts: Establishing a novel era in cancer theranostics. Mater. Res. Express 2019, 6, 102005. [Google Scholar] [CrossRef]
- Bhatt, L.R.; Wagle, B.; Adhikari, M.; Bhusal, S.; Giri, A.; Bhattarai, S. Antioxidant Activity, Total Phenolic and Flavonoid Content of Berberis aristata DC. and Berberis thomsoniana CK Schneid. from Sagarmatha National Park, Nepal. Pharmacog. J. 2018, 10, s167–s171. [Google Scholar] [CrossRef]
- Gundogdu, M. Determination of antioxidant capacities and biochemical compounds of Berberis vulgaris L. fruits. Adv. Environ. Biol. 2013, 7, 344–348. [Google Scholar]
- Batool, F.; Saadullah, M.; Asif, M.; Uzair, M.; Choudhary, B.A.; Afzal, S.; Tareen, R.B. Phytochemical and biological screening of root extracts of Berberis baluchistanica. BioCell 2019, 43. Available online: https://www.semanticscholar.org/paper/Phytochemical-and-biological-screening-of-root-of-Batool-Saadullah/8d55327f51b0ea12221fb3db8dacefcbd9b41b06 (accessed on 28 January 2022).
- Baloch, N.; Nabi, S.; Yasser, M.; Kahraman, A. In vitro antileishmanial, cytotoxic, anti-oxidant activities and phytochemical analysis of Berberis baluchistanica roots extracts and its fractions. J. Phytopharmacol. 2013, 4, 282–287. [Google Scholar]
- Belwal, T.; Bhatt, I.D.; Rawal, R.S.; Pande, V. Microwave-assisted extraction (MAE) conditions using polynomial design for improving antioxidant phytochemicals in Berberis asiatica Roxb. ex DC. leaves. Ind. Crops Prod. 2017, 95, 393–403. [Google Scholar] [CrossRef]
- Karimkhani, M.; Salarbashi, D.; Sefidy, S.S.; Mohammadzadeh, A. Effect of extraction solvents on lipid peroxidation, antioxidant, antibacterial and antifungal activities of Berberis orthobotrys Bienerat ex CK Schneider. J. Food Meas. Charact. 2019, 13, 357–367. [Google Scholar] [CrossRef]
- Elzaawely, A.A.; Xuan, T.D.; Koyama, H.; Tawata, S. Antioxidant activity and contents of essential oil and phenolic compounds in flowers and seeds of Alpinia zerumbet (Pers.) BL Burtt. & RM Sm. Food Chem. 2007, 104, 1648–1653. [Google Scholar]
- Peterson, J.; Dwyer, J. Flavonoids: Dietary occurrence and biochemical activity. Nutr. Res. 1998, 18, 1995–2018. [Google Scholar] [CrossRef]
- WHO. Vitamin and Mineral Requirements in Human Nutrition; World Health Organization: Geneva, Switzerland, 2004. [Google Scholar]
- Osawa, T. Novel natural antioxidants for utilization in food and biological systems. Postharvest Biochem. Plant Food-Mater. Trop. 1994, 1, 241–251. [Google Scholar]
- Masek, A.; Latos-Brozio, M.; Chrzescijanska, E.; Podsedek, A. Polyphenolic Profile and Antioxidant Activity of Juglans regia L. Leaves and Husk Extracts. Forests 2019, 10, 988. [Google Scholar] [CrossRef]
- Jain, P.; Soni, A.; Jain, P.; Bhawsar, J. Phytochemical analysis of Mentha spicata plant extract using UV-VIS, FTIR and GC/MS technique. J. Chem. Pharmac. Res. 2016, 8, 1–6. [Google Scholar]
- Maobe, M.A.; Nyarango, R.M. Fourier transformer infra-red spectrophotometer analysis of Warburgia ugandensis medicinal herb used for the treatment of diabetes, malaria and pneumonia in Kisii Region, Southwest Kenya. Glob. J. Pharmacol. 2013, 7, 61–68. [Google Scholar]
- Saxena, S.; Negi, R.; Guleri, S. Antimicrobial potential of Berberis aristata DC against some human bacterial pathogens. Mycopathol. Res. 2014, 52, 227–235. [Google Scholar]
- Velioglu, Y.; Mazza, G.; Gao, L.; Oomah, B. Antioxidant activity and total phenolics in selected fruits, vegetables, and grain products. J. Agric. Food Chem. 1998, 46, 4113–4117. [Google Scholar] [CrossRef]
- Fernández-Poyatos, M.d.P.; Ruiz-Medina, A.; Zengin, G.; Llorent-Martínez, E. Phenolic characterization, antioxidant activity, and enzyme inhibitory properties of Berberis thunbergii DC. leaves: A valuable source of phenolic acids. Molecules 2019, 24, 4171. [Google Scholar] [CrossRef] [PubMed]
- Akhtar, N.; Mirza, B. Phytochemical analysis and comprehensive evaluation of antimicrobial and antioxidant properties of 61 medicinal plant species. Arab. J. Chem. 2018, 11, 1223–1235. [Google Scholar] [CrossRef]
- Malik, A.; Najda, A.; Bains, A.; Nurzyńska-Wierdak, R.; Chawla, P. Characterization of citrusnobilis peel methanolic extract for antioxidant, antimicrobial, and anti-inflammatory activity. J. Mol. 2021, 26, 4310. [Google Scholar] [CrossRef] [PubMed]
- Bains, A.; Chawla, P. In vitro bioactivity, antimicrobial and anti-inflammatory efficacy of modified solvent evaporation assisted Trametes versicolor extract. J. Biotech. 2020, 10, 1–11. [Google Scholar] [CrossRef] [PubMed]
- Iqbal, J.; Abbasi, B.A.; Ahmad, R.; Mahmoodi, M.; Munir, A.; Zahra, S.A.; Shahbaz, A.; Shaukat, M.; Kanwal, S.; Uddin, S. Phytogenic Synthesis of Nickel Oxide Nanoparticles (NiO) Using Fresh Leaves Extract of Rhamnus triquetra (Wall.) and Investigation of Its Multiple In Vitro Biological Potentials. Biomedicines 2020, 8, 117. [Google Scholar] [CrossRef] [PubMed]
- Iqbal, J.; Abbasi, B.A.; Mahmood, T.; Hameed, S.; Munir, A.; Kanwal, S. Green synthesis and characterizations of Nickel oxide nanoparticles using leaf extract of Rhamnus virgata and their potential biological applications. Appl. Organomet. Chem. 2019, 33, e4950. [Google Scholar] [CrossRef]
- Abbasi, B.A.; Iqbal, J.; Khan, Z.; Ahmad, R.; Uddin, S.; Shahbaz, A.; Zahra, S.A.; Shaukat, M.; Kiran, F.; Kanwal, S. Phytofabrication of cobalt oxide nanoparticles from Rhamnus virgata leaves extract and investigation of different bioactivities. Microsc. Res. Tech. 2021, 84, 192–201. [Google Scholar] [CrossRef]
- Khalil, A.T.; Ovais, M.; Ullah, I.; Ali, M.; Shinwari, Z.K.; Hassan, D.; Maaza, M. Sageretia thea (Osbeck.) modulated biosynthesis of NiO nanoparticles and their in vitro pharmacognostic, antioxidant and cytotoxic potential. Artif. Cells Nanomed. Biotechnol. 2018, 46, 838–852. [Google Scholar] [CrossRef] [PubMed]
- Parthasarathy, S.; Jayacumar, S.; Chakraborty, S.; Soundararajan, P.; Joshi, D.; Gangwar, K.; Bhattacharjee, A.; Venkatesh, M.P.D. Fabrication and characterization of copper nanoparticles by green synthesis approach using Plectranthus amboinicus leaves extract. Res. Seq. 2020. [Google Scholar] [CrossRef]
- Abbasi, B.A.; Iqbal, J.; Kiran, F.; Ahmad, R.; Kanwal, S.; Munir, A.; Uddin, S.; Nasir, J.A.; Chalgham, W.; Mahmood, T. Green formulation and chemical characterizations of Rhamnella gilgitica aqueous leaves extract conjugated NiONPs and their multiple therapeutic properties. J. Mol. Struct. 2020, 1218, 128490. [Google Scholar] [CrossRef]
- Ghorbanpour, M.; Wani, S.H. Advances in Phytonanotechnology: From Synthesis to Application; Academic Press: Cambridge, MA, USA, 2019. [Google Scholar]
- Jesudoss, S.; Vijaya, J.J.; Kennedy, L.J.; Rajan, P.I.; Al-Lohedan, H.A.; Ramalingam, R.J.; Kaviyarasu, K.; Bououdina, M. Studies on the efficient dual performance of Mn1–xNixFe2O4 spinel nanoparticles in photodegradation and antibacterial activity. J. Photochem. Photobiol. Biol. 2016, 165, 121–132. [Google Scholar] [CrossRef] [PubMed]
- Chawla, P.; Kumar, N.; Bains, A.; Dhull, S.B.; Kumar, M.; Kaushik, R.; Punia, S. Gum arabic capped copper nanoparticles: Synthesis, characterization, and applications. Int. J. Biol. Macromol. 2020, 146, 232–242. [Google Scholar] [CrossRef] [PubMed]
- Ali, M.; Haroon, U.; Khizar, M.; Chaudhary, H.J.; Hussain Munis, M.F. Scanning electron microscopy of bio-fabricated Fe2O3 nanoparticles and their application to control brown rot of citrus. Microsc. Res. Tech. 2021, 84, 101–110. [Google Scholar] [CrossRef] [PubMed]
- Khalil, A.T.; Ovais, M.; Ullah, I.; Ali, M.; Shinwari, Z.K.; Maaza, M. Physical properties, biological applications and biocompatibility studies on biosynthesized single phase cobalt oxide (Co3O4) nanoparticles via Sageretia thea (Osbeck.). Arab. J. Chem. 2020, 13, 606–619. [Google Scholar] [CrossRef]
- Huang, W.; Yan, M.; Duan, H.; Bi, Y.; Cheng, X.; Yu, H. Synergistic antifungal activity of green synthesized silver nanoparticles and epoxiconazole against Setosphaeria turcica. J. Nanomat. 2020, 2020, 7. [Google Scholar] [CrossRef]
- Sabouri, Z.; Rangrazi, A.; Amiri, M.S.; Khatami, M.; Darroudi, M.J.B.; Engineering, B. Green synthesis of nickel oxide nanoparticles using Salvia hispanica L.(chia) seeds extract and studies of their photocatalytic activity and cytotoxicity effects. J. Bioprocess Biosyst. Eng. 2021, 44, 2407–2415. [Google Scholar] [CrossRef]
- Lin, D.; Xing, B.J.E.p. Phytotoxicity of nanoparticles: Inhibition of seed germination and root growth. J. Environ. Poll. 2007, 150, 243–250. [Google Scholar] [CrossRef] [PubMed]
- Szőllősi, R.; Molnár, Á.; Kondak, S.; Kolbert, Z.J.P. Dual effect of nanomaterials on germination and seedling growth: Stimulation vs. phytotoxicity. J. Plants 2020, 9, 1745. [Google Scholar] [CrossRef] [PubMed]
- Khalaki, M.A.; Moameri, M.; Lajayer, B.A.; Astatkie, T. Influence of nano-priming on seed germination and plant growth of forage and medicinal plants. J. Plant Growth Regul 2020, 93, 13–28. [Google Scholar] [CrossRef]
- Maroufpoor, N.; Mousavi, M.; Hatami, M.; Rasoulnia, A.; Lajayer, B.A. Mechanisms involved in stimulatory and toxicity effects of nanomaterials on seed germination and early seedling growth. In Adva. Phytonanotechnol; Elsevier: Amsterdam, The Netherlands, 2019; pp. 153–181. [Google Scholar]
- Khan, M.I.; Fatima, N.; Shakil, M.; Tahir, M.B.; Riaz, K.N.; Rafique, M.; Iqbal, T.; Mahmood, K. Investigation of in-vitro antibacterial and seed germination properties of green synthesized pure and nickel doped ZnO nanoparticles. Phys. B Condens. Matter 2021, 601, 412563. [Google Scholar] [CrossRef]
- Younes, N.; Hassan, H.S.; Elkady, M.F.; Hamed, A.; Dawood, M.F. Impact of synthesized metal oxide nanomaterials on seedlings production of three Solanaceae crops. Heliyon 2020, 6, e03188. [Google Scholar] [CrossRef] [PubMed]
- F Elkady, M.; Shokry Hassan, H. Equilibrium and dynamic profiles of azo dye sorption onto innovative nano-zinc oxide biocomposite. Curr. Nanosci. 2015, 11, 805–814. [Google Scholar] [CrossRef]
- Hao, Y.; Zhang, Z.-T.; Rui, Y.-K.; Ren, J.-Y.; Hou, T.-Q.; Wu, S.-J.; Rui, M.-M.; Jiang, F.-P.; Liu, L.-M. Effect of different nanoparticles on seed germination and seedling growth in rice. In Proceedings of the 2nd Annual International Conference on Advanced Material Engineering (AME 2016), Wuhan, China, 15–17 April 2016. [Google Scholar]
- Chaudhary, S.; Kaur, Y.; Jayee, B.; Chaudhary, G.R.; Umar, A. NiO nanodisks: Highly efficient visible-light driven photocatalyst, potential scaffold for seed germination of Vigna Radiata and antibacterial properties. J. Clean. Prod. 2018, 190, 563–576. [Google Scholar] [CrossRef]
- Dawood, M.F.; Abeed, A.H.; Aldaby, E.E. Titanium dioxide nanoparticles model growth kinetic traits of some wheat cultivars under different water regimes. Plant Physiol. Rep. 2019, 24, 129–140. [Google Scholar] [CrossRef]
- Zulfiqar, F.; Navarro, M.; Ashraf, M.; Akram, N.A.; Munné-Bosch, S. Nanofertilizer use for sustainable agriculture: Advantages and limitations. J. Plant Sci. 2019, 289, 110270. [Google Scholar] [CrossRef]
- Chlopicka, J.; Pasko, P.; Gorinstein, S.; Jedryas, A.; Zagrodzki, P. Total phenolic and total flavonoid content, antioxidant activity and sensory evaluation of pseudocereal breads. Food Sci. Tech. 2012, 46, 548–555. [Google Scholar] [CrossRef]
- Chang, C.-C.; Yang, M.-H.; Wen, H.-M.; Chern, J.-C. Estimation of total flavonoid content in propolis by two complementary colorimetric methods. J. Food Drug Anal. 2002, 10, 3. [Google Scholar]
- Phull, A.-R.; Abbas, Q.; Ali, A.; Raza, H.; Zia, M.; Haq, I.-u. Antioxidant, cytotoxic and antimicrobial activities of green synthesized silver nanoparticles from crude extract of Bergenia ciliata. Future J. Pharm. Sci. 2016, 2, 31–36. [Google Scholar] [CrossRef]
- Singh, J.; Tripathi, N. Inhibition of storage fungi of blackgram (Vigna mungo L.) by some essential oils. Flavour Fragr. J. 1999, 14, 1–4. [Google Scholar] [CrossRef]
- Meyer, B.; Ferrigni, N.; Putnam, J.; Jacobsen, L.; Nichols, D.J.; McLaughlin, J.L. Brine shrimp: A convenient general bioassay for active plant constituents. J. Planta Med. 1982, 45, 31–34. [Google Scholar] [CrossRef] [PubMed]
- Rossello, J.A.; Mayol, M. Seed germination and reproductive features of Lysimachia minoricensis (Primulaceae), a wildextinct plant. Ann. Bot. 2002, 89, 559–562. [Google Scholar] [CrossRef] [PubMed][Green Version]
- Hernández-Herrera, R.M.; Santacruz-Ruvalcaba, F.; Ruiz-López, M.A.; Norrie, J.; Hernández-Carmona, G. Effect of liquid seaweed extracts on growth of tomato seedlings (Solanum lycopersicum L.). J. Appl. Phycol. 2014, 26, 619–628. [Google Scholar] [CrossRef]
- Waghulde, S.; Kale, M.K.; Patil, V. Brine Shrimp Lethality Assay of the Aqueous and Ethanolic Extracts of the Selected Species of Medicinal Plants. Multidiscip. Digit. Publ. Inst. Proc. 2019, 41, 47. [Google Scholar]
- Hayes, A.W.; Kruger, C.L. Hayes’ Principles and Methods of Toxicology; CRC Press: Boca Raton, FL, USA, 2014. [Google Scholar]

| Peak Values (cm−1) | Strength | Functional Groups | Interpretations |
|---|---|---|---|
| 3278.91 | Medium | OH | Phenol, Alcohol |
| 2981.10–2840.51 | Medium | C-H | Alkane |
| 1645.87 | Medium | C=N | Imine |
| 1396.31 | Weak | C=C | Aromatic compounds |
| 1114.94–1013.15 | Weak | C–O | Alcohol, ether |
| 550.9 | Medium | C-Cl | Alkyl halides |
| No | 2θB | θB | 2Θ1 | 2Θ2 | Interplanar Spacing d (A°) | (nm) | Miller Indices (hkl) | |
|---|---|---|---|---|---|---|---|---|
| 1 | 37.04° | 18.52° | 36.75° | 37.41° | 0.00575 | 2.41200 | 24.7 nm | (003) |
| 2 | 43.12° | 21.56° | 42.47° | 43.53° | 0.00925 | 2.08900 | 15.69 nm | (012) |
| 3 | 62.77° | 31.38° | 62.45° | 63.09° | 0.00558 | 1.47700 | 28.33 nm | (104) |
Publisher’s Note: MDPI stays neutral with regard to jurisdictional claims in published maps and institutional affiliations. |
© 2022 by the authors. Licensee MDPI, Basel, Switzerland. This article is an open access article distributed under the terms and conditions of the Creative Commons Attribution (CC BY) license (https://creativecommons.org/licenses/by/4.0/).
Share and Cite
Uddin, S.; Iqbal, J.; Safdar, L.B.; Ahmad, S.; Abbasi, B.A.; Capasso, R.; Kazi, M.; Quraihi, U.M. Green Synthesis of BPL-NiONPs Using Leaf Extract of Berberis pachyacantha: Characterization and Multiple In Vitro Biological Applications. Molecules 2022, 27, 2064. https://doi.org/10.3390/molecules27072064
Uddin S, Iqbal J, Safdar LB, Ahmad S, Abbasi BA, Capasso R, Kazi M, Quraihi UM. Green Synthesis of BPL-NiONPs Using Leaf Extract of Berberis pachyacantha: Characterization and Multiple In Vitro Biological Applications. Molecules. 2022; 27(7):2064. https://doi.org/10.3390/molecules27072064
Chicago/Turabian StyleUddin, Siraj, Javed Iqbal, Luqman Bin Safdar, Saleem Ahmad, Banzeer Ahsan Abbasi, Raffaele Capasso, Mohsin Kazi, and Umar Masood Quraihi. 2022. "Green Synthesis of BPL-NiONPs Using Leaf Extract of Berberis pachyacantha: Characterization and Multiple In Vitro Biological Applications" Molecules 27, no. 7: 2064. https://doi.org/10.3390/molecules27072064
APA StyleUddin, S., Iqbal, J., Safdar, L. B., Ahmad, S., Abbasi, B. A., Capasso, R., Kazi, M., & Quraihi, U. M. (2022). Green Synthesis of BPL-NiONPs Using Leaf Extract of Berberis pachyacantha: Characterization and Multiple In Vitro Biological Applications. Molecules, 27(7), 2064. https://doi.org/10.3390/molecules27072064

